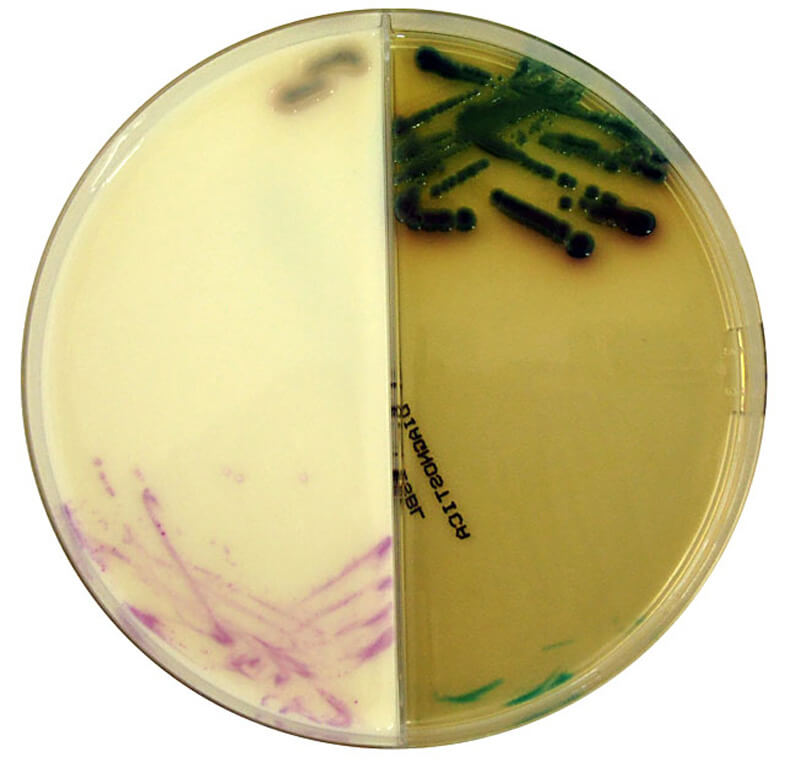

À propos du produit
CHROMagar VRE est utilisé pour la détection des entérocoques résistants à la vancomycine Van A / Van B.
Slanetz Bartley est utilisé pour la détection et l'énumération des entérocoques.
Produits
Milieux et suppléments
Géloses Chromogènes CHROMagar
CHROMAGAR VRE / SLANETZ BARTLEY AGAR
CHROMAGAR VRE / SLANETZ BARTLEY AGAR
CHROMagar VRE est utilisé pour la détection des entérocoques résistants à la vancomycine Van A / Van B.
Slanetz Bartley est utilisé pour la détection et l'énumération des entérocoques.